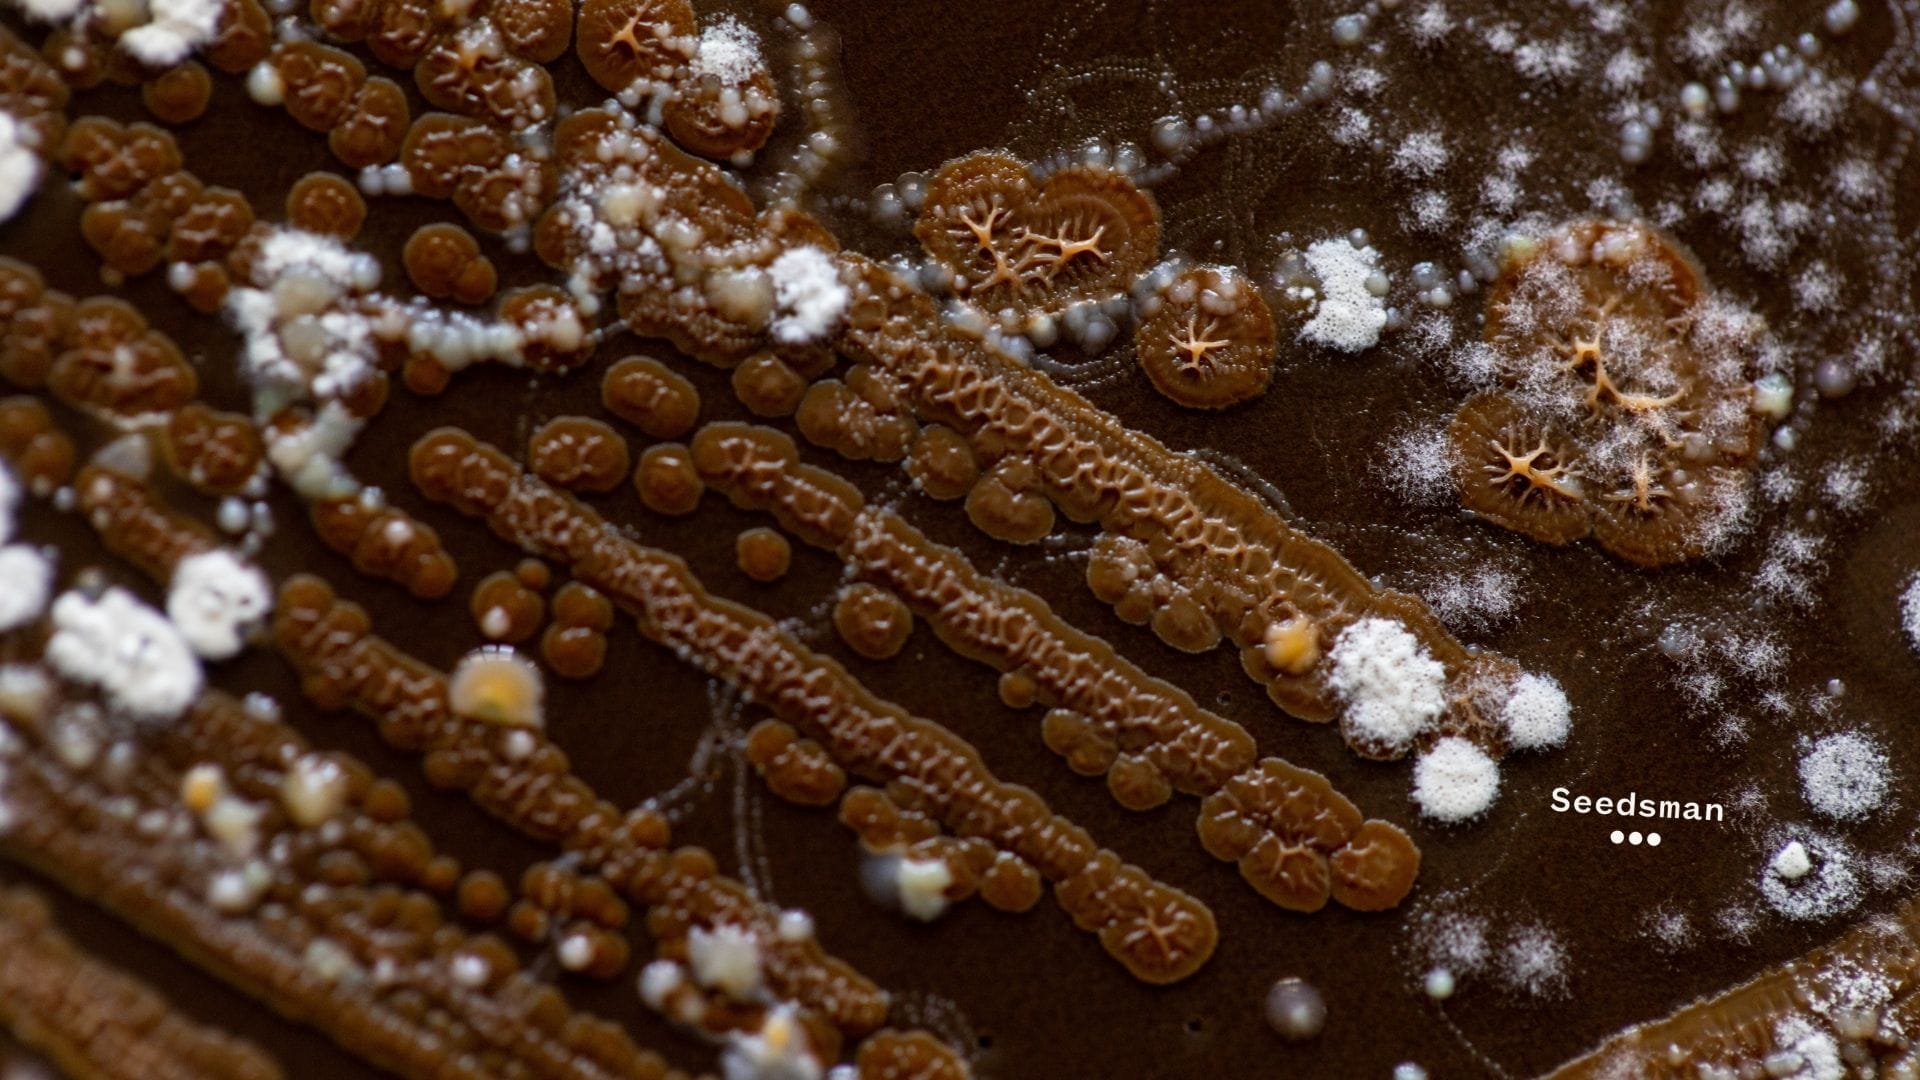

La solution microbienne JADAM est extrêmement puissante pour votre sol qui a déjà gagné le cœur de nombreux autoproducteurs. Vous vous demandez peut-être ce dont il s’agit. Si c'est le cas, lisez ce qui suit.
Dans cet article, je vais répondre aux questions que vous vous posez sans doute à ce sujet et vous expliquer comment produire vous-même cette merveille. Comme vous le verrez, le JADAM est une solution étonnante à ajouter à votre arsenal d'amendements naturels faits maison.
Les origines du JADAM
Parlons d'abord d'agriculture organique coréenne avant de parler de la JADAM. En effet, le JADAM est née de l'agriculture organique coréenne (AOC) dans les années 60, avec le Dr Cho Han Kyu. Le Dr Cho voulait apporter quelque chose à l'agriculture occidentale qui empêcherait le lessivage de la terre. Il a contribué à révolutionner l'agriculture pour qu'elle devienne autosuffisante à un coût minimal pour l'agriculteur.
Plus tard, c’est son fils, Youngsang Cho, a pris la relève de son père et a perfectionné l’AOC, y ajoutant le JADAM. JADAM est l'abréviation de Jayonul Damun Saramdul (le nom de l'organisation créée par M. JADAM est l'abréviation de Jayonul Damun Saramdul (le nom de l'organisation créée par M. Mais le JADAM est plus qu'une simple solution microbienne. Il s'agit d'une forme d'agriculture tendant vers le tout organique.
Sur quels principes repose le JADAM ?
Comme l’AOC, le JADAM est une méthode d'agriculture naturelle qui élimine presque tous les coûts. C’est une série de principes simples et faciles à suivre. M. Cho utilise la méthode scientifique pour prouver que cette façon de traiter le sol fonctionne mieux que n'importe quel autre engrais, revitalisant le sol à des niveaux plus profonds, quelque chose qu’aucun produit vendu en magasin n’est capable de réaliser. Il suffit de se servir de matériaux trouvés dans la nature. En fait, le JADAM consiste à copier le sol de la forêt dans votre propre jardin.
Des microorganismes dans votre sol
Le JADAM permet d'apporter une multitude de micro-organismes à votre sol. Il permet donc d’ameublir le sol, empêcher le compactage, de retenir l'eau, et même de garder les organismes/micro-organismes non bénéfiques à distance. Ce système est extrêmement efficace car, lorsque vous apportez ces organismes depuis sol de la forêt (où il y a un cycle presque parfait de vie, de mort, de décomposition et de retour à la vie), vous apportez à la fois les « bons » et les « mauvais »" microbes, pour créer un équilibre dans ce sol.
Remarquez que j'ai mis des guillemets à « bons » et « mauvais ». Ce n’est pas pour rien. L’AOC ne considère pas les micro-organismes comme bonsou mauvais, mais voit plutôt l’équilibre entre eux. Des « mauvais » sont indispensables au bien-être des « bons » qui s’en nourrissent et à celui des plantes et/ou des cultures qui peuvent ainsi développer un système immunitaire sain et fort. Tout est question d’équilibre.
Pourquoi recourir au JADAM ?
Le JADAM permet de développer une parcelle de sol saine dans laquelle faire pousser tout et n’importe quoi, un sol qui conservera sa santé même après la récolte.
Comment produire votre propre JADAM ?
La fabrication du JADAM est extrêmement simple. Vous aurez seulement besoin d'un seau de 20 litres et de 15 litres d'eau sans chlore, chloramine ou fluorure. Vous aurez également besoin d'un bâton pour suspendre vos pommes de terre et vos feuilles, d’un demi-kilo de pommes de terre, de sel de mer (il faut que ce soit du sel de mer, sinon la solution ne fonctionnera pas du tout ou ne sera pas aussi puissante) ou d'eau de mer, de vieilles chaussettes ou de collants et, enfin, de feuilles avec de terre.
C'est tout. Tout ce que vous allez faire, c'est vous rendre dans les bois et trouver un endroit couvert de feuilles mortes. Ensuite, balayez-les. En dessous, vous devriez voir quelque chose qui ressemble à de la terre très foncée. C'est de la moisissure de feuilles.

Récoltez-la ainsi qu'un centimètre de la terre qui se trouve en dessous. Vous pouvez aisément remarquer certains microbes ressemblant à des toiles d'araignée. Récoltez-les également. En voici des photos :


Une fois cette matière récoltée, faites cuire vos pommes de terre jusqu'à ce qu'elles soient molles et faciles à écraser. Laissez-les ensuite refroidir, puis munissez-vous de tous les autres produits nécessaires (ceux mentionnés plus haut) car il est temps de lancer le processus. En voici les étapes.
Les étapes de la préparation du JADAM
1. Prenez le sel de mer et versez-en environ 15 grammes (les mesures n'ont pas besoin d'être exactes) à votre eau. Si vous utilisez de l'eau de mer, ajoutez-en environ 30 grammes supplémentaire.
2. Placez vos pommes de terre à l’intérieur d’une vieille chaussette ou d’un collant, et à l’aide du bâton, suspendez-les immergées dans l’eau.
3. Prenez ensuite la terre récoltée dans la forêt, mettez-la dans une autre chaussette/collant et suspendez-la à côté des pommes de terre.
4. Pressez ces chaussettes/collants jusqu'à ce que l’eau devienne s’assombrisse.
5. Faites de même avec les pommes de terre, en veillant à bien les écraser. Vous pourrez alors voir de la mousse se former. C'est un excellent signe.
6. Recouvrez alors votre seau d'un sac en plastique ou d'un tissu léger, et placez-le dans un endroit dont la température correspond à celle de votre sol ou de votre chambre de culture. Vous serez ainsi sûr d'obtenir les micro-organismes correspondant à cette plage de température.
7. Laissez reposer le tout pendant 2 à 5 jours. Tout dépend de la météo. Si le temps est chaud, le processus est plus rapide.
Lorsque le brassage est terminé, vous devriez voir une bonne quantité de mousse. C'est que tout a bien fonctionné. Vous voulez utiliser cette solution tout de suite. Diluez-la dans un rapport de 1:20 (10 ml de cette solution pour 200 ml d'eau, par exemple). Ensuite, arrosez le sol autour de vos plantes. Si vous l'utilisez en pulvérisation foliaire, ne mélangez que dans un rapport de 1:100. Vous trouverez ci-dessous des photos :



Comme vous pouvez le voir, au bout de deux jours, de la mousse apparait à la surface. Il se peut, par ailleurs, que vous remarquiez une odeur puissante. C'est tout à fait normal. Ce sont les microbes qui contribuent à la vie de votre sol qui en sont responsables. Ce produit permet, en effet, le développement des bactéries (plus que n’importe quel produit développé par l'homme), des nématodes et d'autres formes de micro-organismes qui font de votre sol un sol vivant. Diluez ce produit dans un rapport de 1:20. Ensuite, il vous suffit d'arroser vos plantes avec.
Amélioration de la santé du sol
Le JADAM permet le développement des microbes de la forêt au sein même de votre sol. Il améliore de la sorte sa santé en faisant de votre sol un sol vivant. Si vous avez des problèmes de compactage, le produit aidera à les briser. À l’inverse, si votre sol est sablonneux et que son drainage est excessif, l'ajout de ce produit en fera un environnement de culture idéal.
Des plantes en pleine forme
Vos plantes vont adorer. Bien que cette préparation paraisse sale, il s’agit en fait simplement d’une sorte de bain pour les racines d'une plante. Si vous aimez cultiver en pleine terre, faites un essai. On ne sait jamais. Vos plantes vous en seront reconnaissantes.